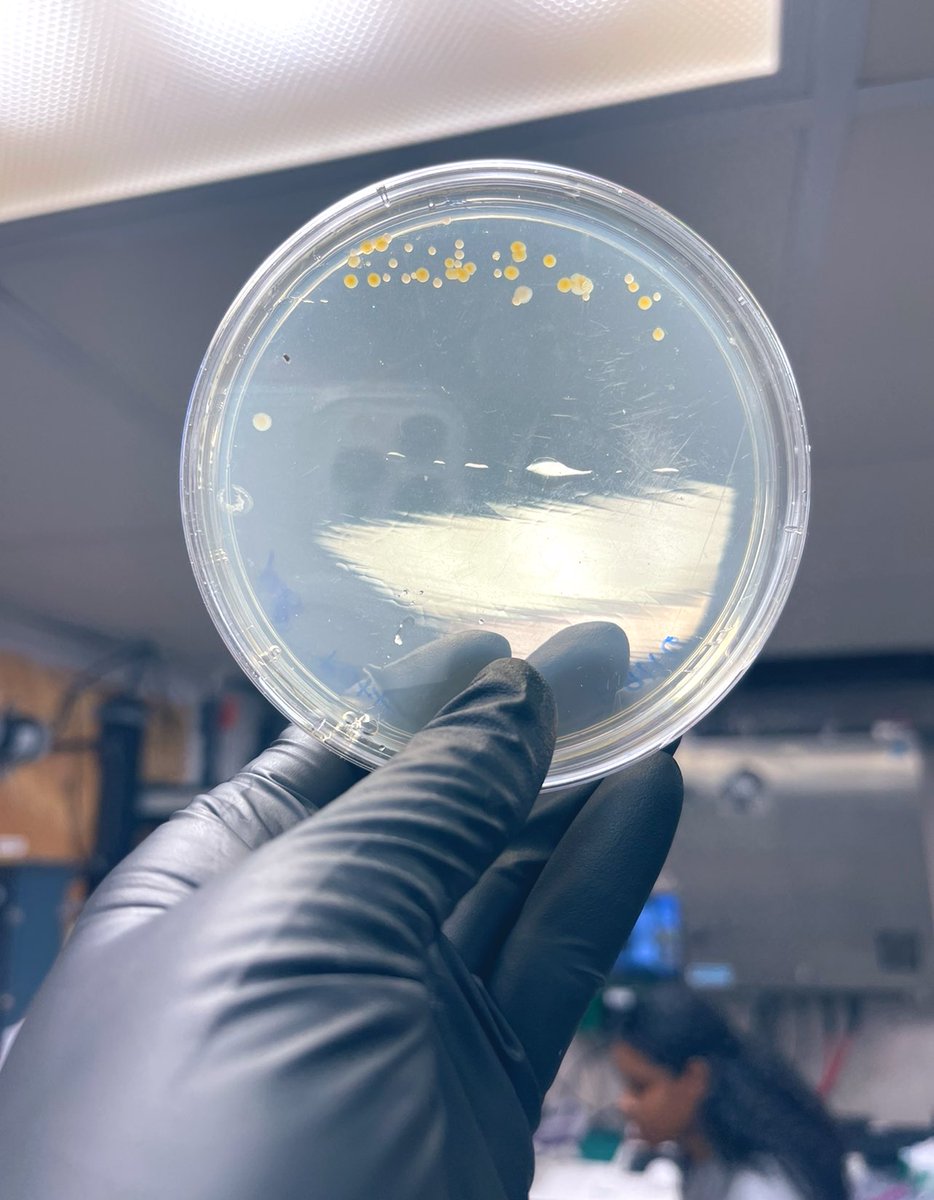
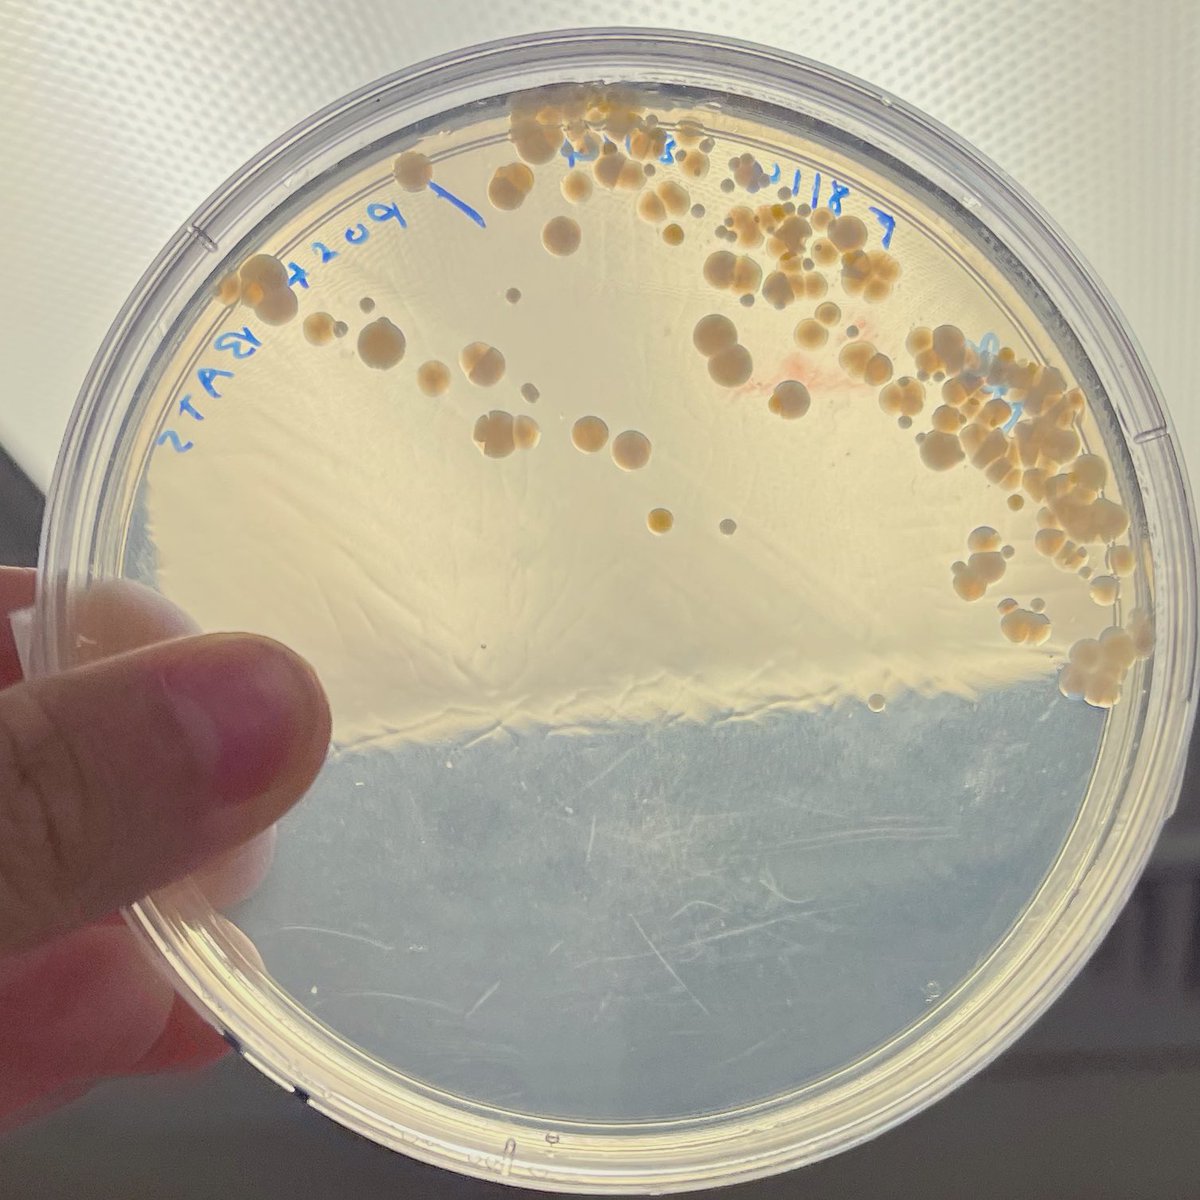

Anjali Bhatnagar (she/her)
@anjbhatnagar
PhD student in Webb lab at USC
ID: 1294069518772441088
14-08-2020 00:33:24
4 Tweet
100 Followers
187 Following


Our last #TRoL cruise of the season with the amazing Anjali Bhatnagar (she/her) and ShelbyJBarnes starting ~75 Trichodesmium cultures among many other things !🧫😄 Bermuda Atlantic Time-Series Study (BATS 🦇)